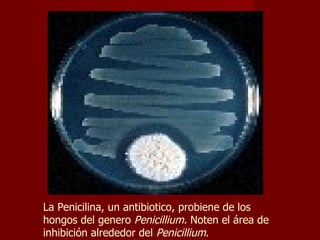
La Penicilina, un antibiotico, probiene de los hongos del genero  Penicillium.  Noten el área de inhibición alrededor del  Penicillium .

Las bacterias son organismos unicelulares que se dividen en dos dominios principales: Archaebacteria y Eubacteria. Las bacterias pueden ser autotrófas u heterótrofas dependiendo de cómo obtienen energía, y aerobias u anaerobias dependiendo de si requieren oxígeno. Dentro de los Archaebacteria se encuentran las metanógenas, halofilas y termofilas, mientras que los Eubacteria incluyen las cianobacterias. Las bacterias juegan un papel fundamental en procesos como la fotosíntesis, la descomposición de